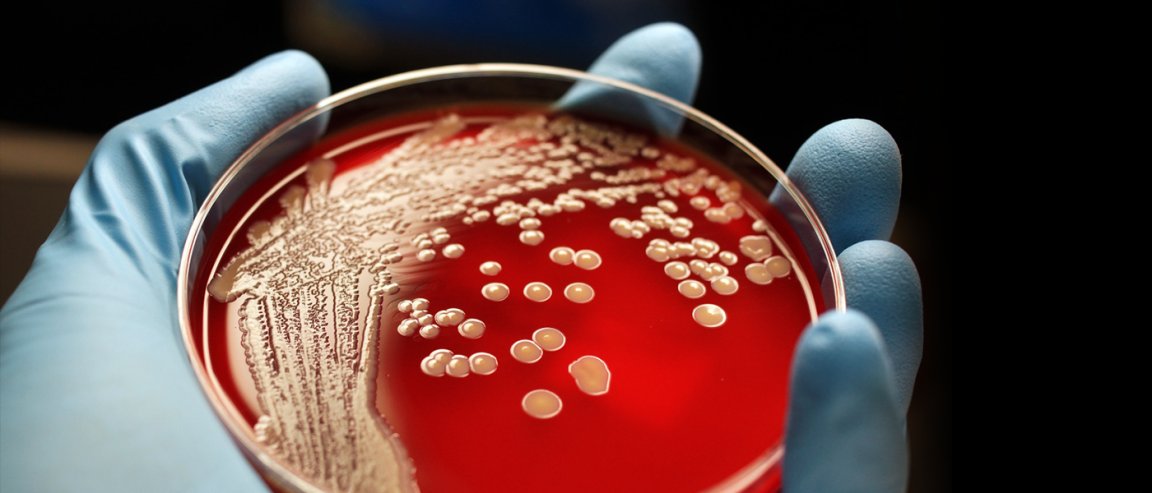

Superbug Rising
While researchers have been hard at work looking for new kinds of medicine to treat pathogens, they have been fighting a losing battle to drug-resistant bacteria. A growing concern in many parts of the world, this drug-resistance problem has been festering due to a lack of joint efforts to combat the threat.
That may be about to change. This issue is so large now that the UN General Assembly will gather in New York to discuss and deliberate a response to the looming crisis of antimicrobial resistance.
Drug resistance has been an issue for a long time. Even with the introduction of penicillin, bacteria have been adapting to resist the drugs formulated to fight them. However, the fast pace of drug development was able to counter this threat.

Unfortunately, we are now at the bottom of the barrel when we prescribe medicine. Last year, doctors reported a new strain of bacteria resistant to the last-resort drug colistin. Found in Chinese meat products, a resistance to colistin represents a fear among physicians of even our strongest drug becoming ineffective. Luckily, this colistin-resistant strain looks like it can be beaten with other drugs. But it is only a matter of time before different resistances meet in one bacterial strain.
Hopeful of Coordinated Response
This UN meeting may be a signal of the world finally being ready to take this issue seriously. “The previous discussions have been held at the level of ministers of health and agriculture but this meeting will take this up to the level of prime ministers and presidents,” says Keiji Fukuda, special representative of the WHO Director-General for Antimicrobial Resistance, to Scientific American.
While no actual formal declaration or commitment is expected from the meeting, it is a sign of political commitment to the issue, and could possibly trigger more financing.
Teams all around the world are looking at different angles to approach this matter. Some are looking at boosting antibodies to combat the bacteria. Others see bacteriophages (bacterial parasites) as a good weapon against the bacteria. Still, others are researching probiotics to combat bacteria, or finding a way to starve the invaders. Regardless of the avenues taken, more attention and cooperation is needed to resist further resistance.